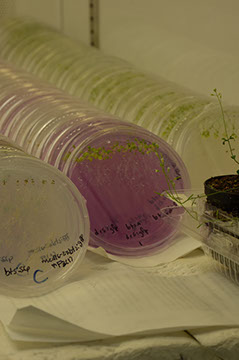

Instituto de Investigaciones Químico Biológicas
Maestría en Ciencias en Biología Experimental

3 - 3
Generación 2015 - 2017 A
Generación 2015 - 2017 B
Generación 2016 - 2018 A
Generación 2016 - 2018 B
** Para la generación 2017-2019A no se abrió convocatoria
Generación 2017 - 2019 B
Generación 2018 - 2020 A
Generación 2018 - 2020 B
Generación 2019 - 2021 A
Generación 2019 - 2021 B
Generación 2020 - 2022 A
Generación 2020 - 2022 B
Generación 2021 - 2023 A
Generación 2021 - 2023 B
Generación 2022 - 2024 A
Estudiantes Titulados previo al 2015
** Estadísticas de la pagina actualizadas el 25 de marzo de 2022
Generación 2015 - 2017 A
CELESTE ALONSO VELÁZQUEZ
Fecha de Titulación: 29 / 03 / 2017
Director de Tesis: Mauro Manuel Martínez Pacheco
LGAC: Bioquímica y Fisiología
CLAUDIA GUADALAUPE FLORES LEDESMA
Fecha de Titulación: 06 / 04 / 2017
Director de Tesis: Christian Cortes Rojo
LGAC: Bioquímica y Fisiología
DANNY PENIEL GARCÍA TREVIÑO
Fecha de Titulación: 05 / 04 / 2017
Director de Tesis: Daniel Godínez Hernández
LGAC: Bioquímica y Fisiología
LIDIA ALEJANDRA ZARAGOZA CAMACHO
Fecha de Titulación: 30 / 03 / 2017
Director de Tesis: Mauro Manuel Martínez Pacheco
LGAC: Bioquímica y Fisiología
MANJURY JATZIRY HERNÁNDEZ ESPARZA
Fecha de Titulación: 07 / 04 / 2017
Director de Tesis: Christian Cortes Rojo
LGAC: Bioquímica y Fisiología
MARÍA GUADALUPE HERNÁNDEZ EQUIHUA
Fecha de Titulación: 25 / 08 / 2017
Director de Tesis: Asdrúbal Aguilera Méndez
LGAC: Bioquímica y Fisiología
NANCY YADIRA REYES MARES
Fecha de Titulación: 08 / 09 / 2017
Director de Tesis: Victor Meza Carmen
LGAC: Bioquímica y Fisiología
SARAÍ ESPARZA REYNOSO
Fecha de Titulación: 24 / 08 / 2017
Director de Tesis: Lourdes Iveth Macías Rodríguez
LGAC: Interacciones Planta Microorganismos
Estudiantes que solicitaron baja temporal
y terminaron con la Generación 2015-2017 B

JOSÉ ALBERTO MARTÍNEZ MORA
Fecha de Titulación: 10 / 11 / 2017
Director de Tesis: Alfredo Saavedra Molina
LGAC: Bioquímica y Fisiología
PAULINA PADILLA MALDONADO
Director de Tesis: Rocío del Carmen Montoya Pérez
LGAC: Bioquímica y Fisiología
Tesis: Efecto de Nicorandil en la atrofia de músculo esquelético en ratones
Estudiantes que causaron baja definitiva

RODOLFO OROZCO GUZMÁN
Fecha de la Baja: 05 / 03/ 2015
ZAIRA JATZIRI TOLEDO LÓPEZ
Fecha de la Baja: 14 / 09 / 2015
Estadísticas de la Generación
Número de Estudiantes: 12
Eficiencia Terminal 58 %
Titulación Corte Generación 75%
Deserción o Baja definitiva: 17%
Generación 2015 - 2017 (B)
ALEJANDRA VARGAS GUERRERO
Fecha de Titulación: 15 / 12 / 2017
Director de Tesis: Jesús Campos García
LGAC: Biotecnología Microbiana y Vegetal
BELEM VARGAS OCHOA
Fecha de Titulación: 25 / 01 / 2018
Director de Tesis: Alfredo Saavedra Molina
LGAC: Bioquímica y Fisiología
ELIZABETH ZETTER SALMÓN
Fecha de Titulación: 28 / 02 / 2018
Director de Tesis: Gustavo Santoyo Pizano
LGAC: Biotecnología Microbiana y Vegetal
GUADALUPE JESSICA SALMERÓN BARRERA
Fecha de Titulación: 27 / 02 / 2018
Director de Tesis: José López Bucio
LGAC: Interacciones Planta Microorganismos

IVÁN CORONA SÁNCHEZ
Fecha de Titulación: 09 / 02 / 2018
Director de Tesis: Homero Reyes de la Cuz
LGAC: Biotecnología Microbiana y Vegetal

JOSÉ ALBERTO PATIÑO MEDINA
Fecha de Titulación: 10 / 11 / 2017
Director de Tesis: Victor Meza Carmen
LGAC: Bioquímica y Fisiología

PEDRO IVÁN HUERTA VENEGAS
Fecha de Titulación: 03 / 05 / 2018
Director de Tesis: José López Bucio
LGAC: Interacciones Planta Microorganismos

RICARDO ESPINO GARCÍA
Fecha de Titulación: 27 / 10 / 2017
Director de Tesis: Asdrúbal Aguilera Méndez
LGAC: Bioquímica y Fisiología
Estadísticas de la Generación
Número de Estudiantes: 8
Eficiencia Terminal 87.5%
Titulación Corte Generación 100%
Deserción o Baja definitiva: 0 %
Generación 2016 - 2018 (A)

BRIAN GÓMEZ CHÁVEZ
Fecha de Titulación: 21 / 03 / 2018
Director de Tesis: Alfredo Saavedra Molina
LGAC: Bioquímica y Fisiología

DANIEL ÁNGEL ÁVILA TORRES
Fecha de Titulación: 24 / 08 / 2018
Director de Tesis: Josué Altamirano Hernández
LGAC: Biotecnología Microbiana y Vegetal

JESÚS ISMAEL ÁVILA LÓPEZ
Director de Tesis: Ernesto García Pineda
LGAC: Biotecnología Microbiana y Vegetal
Tesis: Efecto de Azospirillum brasilense sobre la fosfolipasa C durante su interacción con la planta de trigo

JONANCI ARREOLA RIVERA
fecha de Titulación: 14 / 16 / 2018
Director de Tesis: Elda María Guadalupe Beltrán Peña
LGAC: Biotecnología Microbiana y Vegetal

KASSANDRA MICHELLE REAL SOSA
Fecha de Titulación: 30 / 08 / 2018
Director de Tesis: Eduardo Valencia Cantero
LGAC: Interacciones Planta Microorganismos

MARIANA GÓMEZ BARROSO
fecha de Titulación: 01 / 07 / 2018
Director de Tesis: Rocío del Carmen Montoya Pérez
LGAC: Bioquímica y Fisiología

MARTHA ALICIA MÉNDEZ CAMARILLO
fecha de Titulación: 16 / 08 / 2018
Director de Tesis: Eduardo Valencia Cantero
LGAC: Interacciones Planta Microorganismos

MAYRA XOCHITL DURÁN MALDONADO
fecha de Titulación: 31 / 08 / 2018
Director de Tesis: Jesús Campos García
LGAC: Biotecnología Microbiana y Vegetal

NALLELY SERRATO GAMIÑO
Fecha de Titulación: 16 / 03 / 2018
Director de Tesis: Carlos Cervantes Vega
LGAC: Biotecnología Microbiana y Vegetal

ROBERTO DANIEL IÑAKI DURÁN BALTAZAR
Fecha de Titulación: 28 / 08 / 2018
Director de Tesis: Ernesto García Pineda
LGAC: Biotecnología Microbiana y Vegetal

ROSA ISELA SALINAS ESPINOSA
Fecha de Titulación: 29 / 08 / 2018
Director de Tesis: Rodolfo López Gómez
LGAC: Biotecnología Microbiana y Vegetal
Estadísticas de la Generación
Número de Estudiantes: 11
Eficiencia Terminal 91%
Titulación Corte Generación 91%
Deserción o Baja definitiva: 9 %
Generación 2016 - 2018 (B)

ALEJANDRA YITZEL GUZMÁN HERNÁNDEZ
Fecha del Examen de Titulación: 07 / 06 / 2019
Director de Tesis: Josué Altamirano Hernández
LGAC: Biotecnología Microbiana y Vegetal

ALMA ALEJANDRA HERNÁNDEZ ESQUIVEL
Fecha del Examen de Titulación: 26 / 02 / 2019
Director de Tesis: Ernesto García Pineda
LGAC: Biotecnología Microbiana y Vegetal

ARTURO RAMÍREZ ORDORICA
Fecha del Examen de Titulación: 29 / 11 / 2018
Director de Tesis: Lourdes Iveth Macías Rodríguez
LGAC: Interacciones Planta Microorganismos

BERENICE ERIDANI OLMOS ORIZABA
Fecha del Examen de Titulación: 14 / 12 / 2018
Director de Tesis: Rocío del Carmen Montoya Pérez
LGAC: Bioquímica y Fisiología

BRICIA RUIZ AGUILAR
Fecha del Examen de Titulación: 10 / 10 / 2018
Director de Tesis: José López Bucio
LGAC: Interacciones Planta Microorganismos

CLAUDIA ADILENE LÓPEZ HERNÁNDEZ
Director de Tesis: Jesús Campos García
LGAC: Biotecnología Microbiana y Vegetal
Tesis: Determinación del papel de los ciclodipéptidos ciclo (Pro-Tyr), ciclo (Pro-Phe) y ciclo (Pro-Val) sobre la virulencia de Pseudomonas aeruginosa PAO1

DONOVAN JAVIER PEÑA MONTES
Fecha del Examen de Titulación: 01 / 02 / 2019
Director de Tesis: Alfredo Saavedra Molina
LGAC: Bioquímica y Fisiología

EDGAR HUMBERTO MARÍN AGAPITO
Director de Tesis: Josué Altamirano Hernández
LGAC: Biotecnología Microbiana y Vegetal
Tesis: Estandarización de la producción del pulque y el análisis de la estabilización por pasteurización continua

MELISSA ADRIANA MENDOZA VÁZQUEZ
Fecha del Examen de Titulación: 31 / 10 / 2018
Director de Tesis: Mauro Manuel Martínez Pacheco
LGAC: Bioquímica y Fisiología
Estudiantes que causaron baja definitiva
MALINALI ORTÍZ AMBRIZ
Fecha de la Baja: 28 / 02 / 2017

OMAR OROZCO GRANADOS
Fecha de la Baja: 28 / 02 / 2017
Estadísticas de la Generación
Número de Estudiantes: 11
Eficiencia Terminal 54 %
Titulación Corte Generación 64 %
Deserción o Baja definitiva: 18 %
Generación 2017 - 2019 (B)

JUAN ÁNGEL AYALA RODRÍGUEZ
Fecha del Examen de Titulación: 27 / 09 / 2019
Director de Tesis: José López Bucio
LGAC: Interacciones Planta Microorganismos

LUZMARÍA RAQUEL MORALES CEDEÑO
Fecha del Examen de Titulación: 08 / 11 / 2019
Director de Tesis: Gustavo Santoyo Pizano
LGAC: Interacciones Planta Microorganismos
Estadísticas de la Generación
Número de Estudiantes: 2
Eficiencia Terminal 100%
Titulación Corte Generación 100%
Deserción o Baja definitiva: 0 %
Generación 2018 - 2020 (A)

ELIZABETH CARRILLO FLORES
Tutor: Elda Bentrán Peña
Fecha del Examen de Titulación: 08 / 07 / 2020
LGAC: Biotecnología Microbiana y Vegetal
Estadísticas de la Generación
Número de Estudiantes: 1
Eficiencia Terminal 100%
Titulación Corte Generación 100%
Deserción o Baja definitiva: 0%
Generación 2018 - 2020 (B)

ISRAEL CARBAJAL NÚÑEZ
Fecha del Examen de Titulación: 17 / 06 / 2021
Director de Tesis: Josué Altamirano Hernández
LGAC: Biotecnología Microbiana y Vegetal
KIRÁN RUBÍ JIMÉNEZ VÁZQUEZ

Fecha del Examen de Titulación: 18 / 11 / 2020
Director de Tesis: José López Bucio
LGAC: Interacciones Planta Microorganismos
Estadísticas de la Generación
Número de Estudiantes: 2
Eficiencia Terminal 100%
Titulación Corte Generación 100%
Deserción o Baja definitiva: 0 %
Generación 2019 - 2021 (A)

ALISTAIR HERNÁNDEZ IZQUIERDO
Fecha del Examen de Titulación: 02 / 07 / 2021
Director de Tesis: Mauro M. Martínez Pacheco
LGAC: Bioquímica y Fisiología
Tesis: El antagonismo de rizobacterias y su potencial para controlar los microorganismos causantes de la pudrición peduncular del fruto de aguacate (Persea americana Mill.) en anaquel

AURORA INÉS FLORES PIÑA
Fecha del Examen de Titulación: 25 / 08 / 2021
Director de Tesis: Gustavo Santoyo Pizano
Tesis: Análisis de la estructura y diversidad de comunidades microbianas en suelo a través de un gradiente de temperatura
LGAC: Interacciones Planta Microorganismos

CHYNTIA ADALUZ BANDA CAMPOS
En proceso de titulación
Director de Tesis: Mauro M. Martínez Pacheco
LGAC: Bioquímica y Fisiología
Tesis: Dihidropiridinas modificadas químicamente en la modulación de las enzimas Aldosa reductasa y Sorbitol deshidrogenasa de cristalino de conejo

DIANA ELENA GÓMEZ SÁNCHEZ
En proceso de titulación
Director de Tesis: Jesús Campos García
Tesis: Evaluación de ciclopéptidos bacterianos sobre líneas celulares humanas de leucemia
LGAC: Biotecnología Microbiana y Vegetal

EMANUEL RAMÍREZ VIGIL
En proceso de titulación
Director de Tesis: Homero Reyes de la Cruz
LGAC: Biotecnología Microbiana y Vegetal
Tesis: Evaluación del efecto de los compuestos orgánicos difusibles obtenidos a partir del sistema tripartita de Trichoderma spp / Colletotrichum gloeosporioides
/ Bacillus subtilis sobre los agentes causales de la antracnosis del aguacate in vitro e in vivo

LIZBETH GONZÁLEZ PALOMARES
En proceso de titulación
Director de Tesis: Rocío del Carmen Montoya Pérez
LGAC: Bioquímica y Fisiología
Tesis: Efecto del aceite esencial de Melaleuca alternifolia en el tratamiento local de ulceraciones en piel y músculo en rate Wistar diabética

SANDRA GORETTI ADAME GARNICA
Fecha del Examen de Titulación: 27 / 05 / 2021
Director de Tesis: Lourdes I. Macías Rodríguez
LGAC: Interacciones Planta Microorganismos
Estadísticas de la Generación
Número de Estudiantes: 7
Eficiencia Terminal 43%
Titulación Corte Generación 43%
Deserción o Baja definitiva: 0 %
Generación 2019 - 2021 (B)

BIANCA YARELI ROMÁN CÁRDENAS
Fecha del Examen de Titulación: 14 / 01 / 2022
Director de Tesis: Martha Isela Ramírez Díaz
LGAC: Biotecnología Microbiana y Vegetal
Tesis: Caracterización molecular y funcional de genes del plásmido pum505 que participan en resistencia a quinolonas y en virulencia

CINTHIA ITZEL LANDA MORENO
Fecha del Examen de Titulación: 14 / 12 / 2021
Director de Tesis: Salvador Manzo Ávalos
Tesis: Evaluación de la actividad antioxidante del extracto de acetato de etilo de Potentilla indica en riñones de ratas con diabetes experimental
LGAC: Bioquímica y Fisiología

CRISTIAN MITCHELL TREJO HURTADO
Fecha del Examen de Titulación: 15 / 02 / 2021
Director de Tesis: Alfredo Saavedra Molina
LGAC: Bioquímica y Fisiología
Tesis: Actividad antioxidante y antiinflamatoria del extracto de acetato de etilo de inflorescencias de Eryngium carlinae en hígado de ratas con diabetes
experimental

JENARO LEMUS DE LA CRUZ
Fecha del Examen de Titulación: 16 / 12 / 2021
Director de Tesis: Alfredo Saavedra Molina
Tesis: Efectos antioxidantes de las nanopartículas de plata de síntesis verde sobre el cerebro de ratas con diabetes experimental.
LGAC: Bioquímica y Fisiología

KORÉ MONTSERRATMORENO CALDERÓN
En tramites de titulación
Director de Tesis: Rocío del Carmen Montoya Pérez
LGAC: Bioquímica y Fisiología
Tesis: Efecto del extracto de Eryngium carlinae y el ejercicio sobre el rendimiento muscular en la obesidad

SARAÍ SÁNCHEZ DUARTE
Fecha del Examen de Titulación: 25 / 11 / 2021
Director de Tesis: Rocío del Carmen Montoya Pérez
Tesis: Rol de la NOX2 en músculo esquelético de ratas diabéticas ejercitadas
LGAC: Bioquímica y Fisiología
Estadísticas de la Generación
Número de Estudiantes: 6
Eficiencia Terminal 83%
Titulación Corte Generación 83%
Deserción o Baja definitiva: 0 %
Generación 2020 - 2022 (A)
BIRMANIA RODRÍGUEZ HEREDIA
En proceso de titulación
Director de Tesis: Josué Altamirano Hernández

Tesis: Efecto de la inoculación de bacterias en el vigor y calidad de plantas de agave producidas por micropropagación
LGAC: Biotecnología Microbiana y Vegetal

CARLOS ALBERTO URTIS FLORES
En proceso de titulación
Director de Tesis: Gustavo santoyo Pizano
Tesis: Efecto de la inoculación de Pseudomonas fluorescens UM70 sobre el microbioma rizosférico de maíz (Zea mays) en dos tipos de suelo
LGAC: Interacciones Planta-Microoganismos

DAVID ADRIÁN HERNÁNDEZ GUERRERO
En proceso de titulación
Director de Tesis: Mauro M. Martínez Pacheco
LGAC: Bioquímica y Fisiología
Tesis: Búsqueda de inhibidores de la enzima acetil colinesterasa en Caesalpinia spp y Tabebuia spp

KAREN MONSERRAT GARCÍA VALLE
Fecha del Examen de Titulación: 23 / 03 / 2022
Director de Tesis: José López Bucio
Tesis: Caracterización de la respuesta a serotonina mediada por cinasas MAP y la fosfatasa MKP1 en Arabidopsis thaliana
LGAC: Interacciones Planta-Microoganismos
KATIA LIZBETH ALONSO HURTADO
En proceso de titulación
Director de Tesis: Mauro M. Martínez Pacheco

Tesis: Obtención de lacasas de Fusarium oxysporum con potencial en la degradación de contaminantes fenólicos
LGAC: Bioquímica y Fisiología
MICHELLE ASHANTY DÍAZ PÉREZ
En proceso de titulación
Director de Tesis: Jesús Campos García

Tesis: Participación del sistema inmunológico en el efecto anti-tumoral de ciclodipéptidos en melanoma murino

PATRICIA TORRES SOLORZANO
En proceso de titulación
Director de Tesis: Alfonso Luna Cruz
Tesis: Caracterización y selección de rizobacterias promotoras del crecimiento y su efecto en el rendimiento de jitomete (Solanum lycopersicum L.)
LGAC: Interacciones Planta-Microoganismos
LGAC: Biotecnología Microbiana y Vegetal
Estadísticas de la Generación
Número de Estudiantes: 7
Eficiencia Terminal Marzo - Agosto 2022
Titulación Corte Generación
Deserción o Baja definitiva: 0 %
Generación 2020 - 2022 (B)
ENRIQUE SOTO SUÁREZ
Cuarto Semestre
Director de Tesis: Homero Reyes de la Cruz

Tesis: Análisis del potencial antifúngico de los péptidos antimicrobianos producidos por cepas de Trichoderma spp. aisladas de Los Azufres, Michoacán; sobre el desarrollo de cepas de Fusarium oxysporum resistentes a fungicidas químicos
LGAC: Biotecnología Microbiana y Vegetal

ESTEFANIA BRAVO SÁNCHEZ
Cuarto Semestre
Director de Tesis: Salvador Manzo Ávalos
Tesis: Efecto del diazóxido y el ejercicio sobre el funcionamiento del músculo esquelético de ratas hipertensas
LGAC: Bioquímica y Fisiología

HÉCTOR ANTONIO KIDO DÍAZ
Cuarto Semestre
Director de Tesis: Homero Reyes de la Cruz
LGAC: Biotecnología Microbiana y Vegetal
Tesis: Evaluación del efecto de ciclodipéptidos bacterianos en muestras procedentes de pacientes de leucemia del hospital infantil de Morelia

KENIA YESENIA PEÑALOZA LÓPEZ
Cuarto Semestre
Director de Tesis: Alfredo Saavedra Molina
Tesis: Participación de la NADPH oxidasa durante la diabetes y el ejercicio en músculo cardíaco
LGAC: Bioquímica y Fisiología
OSCAR GERARDO GÁLVEZ COOK
Cuarto Semestre
Director de Tesis: Alfredo Saavedra Molina

Tesis: Efecto de Nitrendipina sobre la Aldolasa en hígado de ratas con diabetes experimental tipo 2
LGAC: Bioquímica y Fisiología
UBER ISAÍ ZARCO RAMÍREZ
Cuarto Semestre
Director de Tesis: Alfonso Luna Cruz

Tesis: Aislamiento y evaluación de hongos entomopatógenos para el control de la chicharrita Empoasca sp. (Hemíptera: Cicadellidae) en el cultivo de papaya
LGAC: Interacciones Planta-Microoganismos
Estadísticas de la Generación
Número de Estudiantes: 6
Eficiencia Terminal Septiembre 2022 - Febrero 2023
Titulación Corte Generación
Deserción o Baja definitiva: 0 %
Generación 2021 - 2023 (A)
ADRIÁN AVALOS RANGEL
Tercer Semestre
Director de Tesis: José López Bucio

Tesis: Función de la subunidad de la RNA polimerasa II, NRPB2 sobre la regeneración de la raíz de Arabidopsis thaliana
LGAC: Interacciones Planta-Microoganismos

CARLA ISABEL TENA FUENTES
Tercer Semestre
Director de Tesis: Jesús Campos García
Tesis: Participación del ORF PA4078 en la virulencia de Pseudomonas aeruginosa PAO1
LGAC: Biotecnología Microbiana y Vegetal

CIELO MARITZA MARTÍNEZ MARTÍNEZ
Tercer Semestre
Director de Tesis: Rocío del Carmen Montoya Pérez
LGAC: Bioquímica y Fisiología
Tesis: Efecto del ejercicio de mediana intensidad sobre la respuesta contráctil, el estrés oxidante y la dinámica de Ca2+ en el músculo esquelético de un modelo de ratón con falla cardíaca con fracción de eyección preservada

XIMENA HERNÁNDEZ RAMOS
Tercer Semestre
Director de Tesis: Jesús Campos García
Tesis: Participación del ORF PA2305/ambB en la virulencia de Pseudomonas aeruginosa PAO1
LGAC: Biotecnología Microbiana y Vegetal
Estadísticas de la Generación
Número de Estudiantes: 4
Eficiencia Terminal Marzo - Agosto 2023
Titulación Corte Generación
Deserción o Baja definitiva: 0 %
Generación 2021 - 2023 (B)
DANIELA GARCÍA GARCÍA
Segundo Semestre
Director de Tesis: Homero Reyes de la Cruz

Tesis: Análisis de la actividad de las proteínas TOR y SnRK1 de Arabidopsis thaliana inducida por factores de virulencia producidos por
Pseudomonas aeruginosa
LGAC: Biotecnología Microbiana y Vegetal

ERENDIRA TUTUTI GUILLEN
Segundo Semestre
Director de Tesis: Josué Altamirano Hernández
Tesis: Efecto de consorcios microbianos en el desarrollo y aclimatación de vitroplantas de Agave cupreata Trel. & A. Berger
LGAC: Biotecnología Microbiana y Vegetal

LIZBETH GUADALUPE VILLALÓN MAGALLÁN
Segundo Semestre
Director de Tesis: Asdrúbal Aguilera Méndez
LGAC: Bioquímica y Fisiología
Tesis: Efectos del consumo de alcohol dependientes de la dosis y del tiempo de exposición sobre la contractilidad vascular adrenérgica α en ratas diabéticas

MARÍA FERNANDA VALENCIA MARÍN
Segundo Semestre
Director de Tesis: Gustavo Santoyo Pizano
Tesis: Análisis de los componentes de membrana de Bacillus halotolerans cepa AF23 y su acción promotora del crecimiento vegetal bajo condiciones de estrés salino
LGAC: Interacciones Planta Microorganismos
SALVADOR CHÁVEZ ÁVILA
Segundo Semestre
Director de Tesis: Gustavo Santoyo Pizano

Tesis: Efecto de la temperatura sobre los componentes de membrana y la acción antifúngica en cepas de Bacillus spp.
LGAC: Interacciones Planta Microorganismos
SAÚL VÁZQUEZ FUENTES
Primer Semestre
Director de Tesis: Jesús Salvador López Bucio

Tesis: Caracterización de los procesos moleculares y celulares inducidos por la N-Vainillil-octanamida sobre el crecimiento y desarrollo del sistema radicular de Arabidopsis thaliana
LGAC: Biotecnología Microbiana y Vegetal
Estadísticas de la Generación
Número de Estudiantes: 6
Eficiencia Terminal Septiembre 2023 - Febrero 2024
Titulación Corte Generación
Deserción o Baja definitiva: 0 %
Generación 2022 - 2024 (A)
BRENDA VALERIO ARELLANO
Primer Semestre
Director de Tesis: Martha Isela Ramírez Díaz

Tesis: Caracterización funcional de las proteínas codificadas por los orfs 90 a 94 de la isla de patogenicidad de pUM505 en la virulencia de
Pseudomonas aeruginosa
LGAC: Biotecnología Microbiana y Vegetal

BRIANDA LIZBETH PAZ CRUZ
Primer Semestre
Director de Tesis: Josué Altamirano Hernández
Tesis: Evaluación de las infusiones de café (Coffea arabica) sobre la protección de la neurodegeneración en Caenorhabditis elegans
LGAC: Biotecnología Microbiana y Vegetal

CHANTAL CHARLOTTE ROSALES CEJA
Primer Semestre
Director de Tesis: Víctor Meza Carmen
LGAC: Bioquímica y Fisiología
Tesis: Papel de la vía de la calcineurina en la regulación del metabolismo oxidativo fermentativo y acumulación de rizoferrina de M. lusitanicus

SERGIO MONTOYA MONTOYA
Primer Semestre
Director de Tesis: Víctor Meza Carmen
Tesis: Dilucidación de la función de los factores de ADP-Ribosilación: Arf3 y Arl1 en la producción de rizoferrina
LGAC: Bioquímica y Fisiología
Estadísticas de la Generación
Número de Estudiantes: 4
Eficiencia Terminal Marzo - Agosto 2024
Titulación Corte Generación
Deserción o Baja definitiva: 0 %





